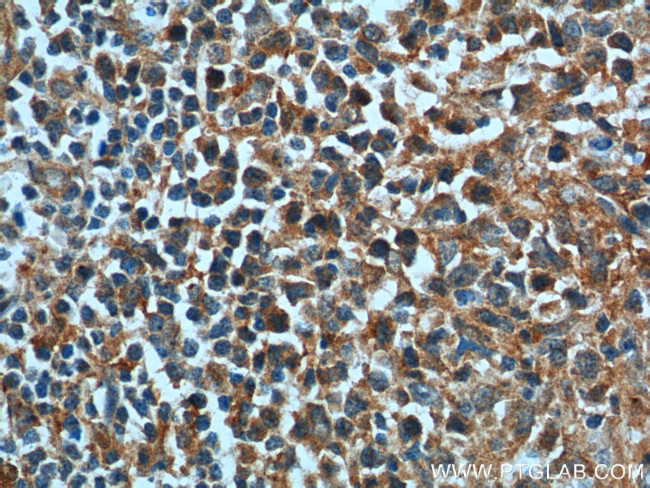
BAD Antibody in Immunohistochemistry (Paraffin) (IHC (P))

Search
Proteintech
BAD Polyclonal Antibody
{{$productOrderCtrl.translations['antibody.pdp.commerceCard.promotion.promotions']}}
{{$productOrderCtrl.translations['antibody.pdp.commerceCard.promotion.viewpromo']}}
{{$productOrderCtrl.translations['antibody.pdp.commerceCard.promotion.promocode']}}: {{promo.promoCode}} {{promo.promoTitle}} {{promo.promoDescription}}. {{$productOrderCtrl.translations['antibody.pdp.commerceCard.promotion.learnmore']}}
产品信息
10435-1-AP
种属反应
已发表种属
宿主/亚型
分类
类型
抗原
偶联物
形式
浓度
规格
纯化类型
保存液
内含物
保存条件
运输条件
产品详细信息
Immunogen sequence: DSSSAERGL GPSPAGDGPS GSGKHHRQAP GLLWDASHQQ EQPTSSSHHG GAGAVEIRSR HSSYPAGTED DEGMGEEPSP FRGRSRSAPP NLWAAQRYGR ELRRMSDEFV DSFKKGLPRP KSAGTATQMR QSSSWTRVFQ SWWDRNLGRG SSAPSQ (14-168 aa encoded by BC001901)
靶标信息
The protein encoded by BAD is a member of the BCL-2 family. BCL-2 family members are known to be regulators of programmed cell death. This protein positively regulates cell apoptosis by forming heterodimers with BCL-xL and BCL-2, and reversing their death repressor activity. Proapoptotic activity of this protein is regulated through its phosphorylation. Protein kinases AKT and MAP kinase, as well as protein phosphatase calcineurin were found to be involved in the regulation of this protein. Alternative splicing of this gene results in two transcript variants which encode the same isoform.
仅用于科研。不用于诊断过程。未经明确授权不得转售。
生物信息学
蛋白别名: BAD; BBC6; Bcl-2-binding component 6; Bcl-2-like protein 8; BCL-X/BCL-2 binding protein; Bcl-xL/Bcl-2-associated death promoter; Bcl2 antagonist of cell death; BCL2-antagonist of cell death protein; Bcl2-associated agonist of cell death; BCL2-binding component 6; BCL2-binding protein; Bcl2-L-8; OTTMUSP00000017561; OTTMUSP00000022400; unnamed protein product
基因别名: BAD; BBC2; BBC6; BCL2L8
UniProt ID: (Human) Q92934
Entrez Gene ID: (Human) 572